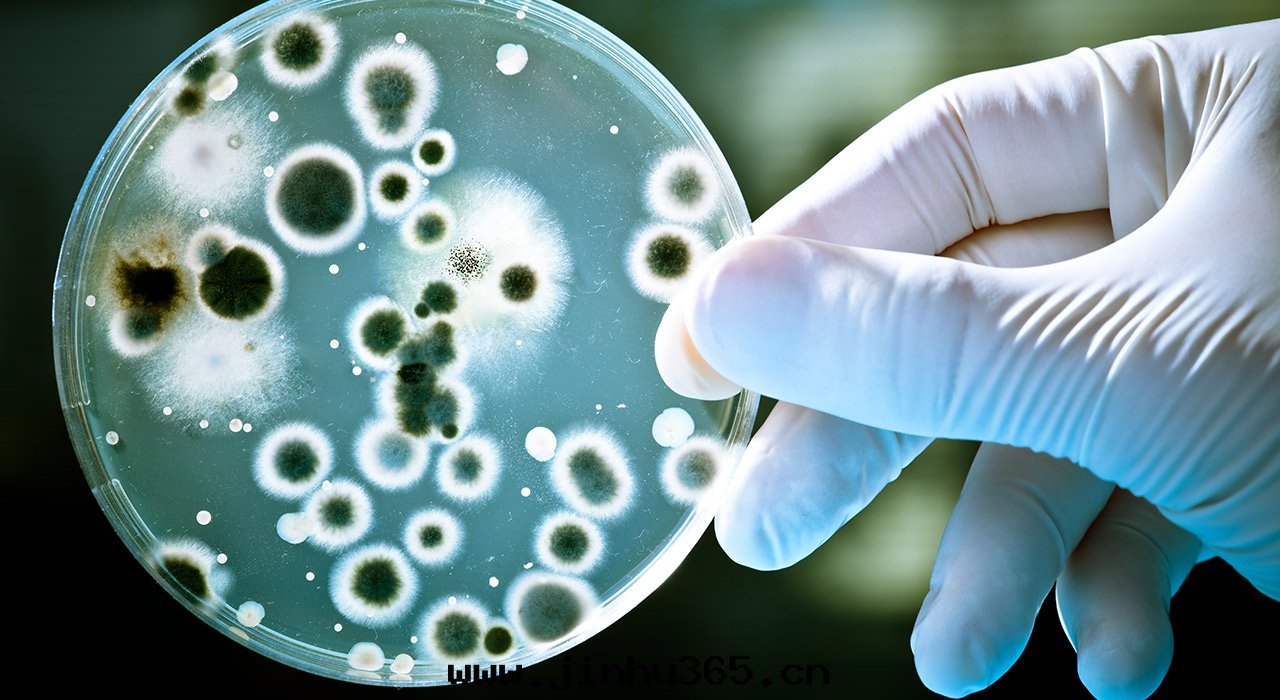

In order to increase the villa area, many villa owners began to dig underground, using it as entertainment room, video room, billiard hall, wine cellar, tea room, lounge and so on. However, the leakage problem is also followed by the basement moisture-proof development of underground space must be faced with a difficult problem.
1, because the builder in the construction of the villa only in the villa basement outdoor waterproof. And the decoration construction unit is in accordance with the national basement leakage warranty for only 5 years to choose materials, coupled with the drawings of the design did not require villa basement internal waterproof moistureproof mildew treatment, so resulting in a large number of villa basement damp mildew breeding!

2, villa basement concrete pouring is not dense, construction joint garbage cleaning is not clean, villa basement concrete floor wall plate temperature cracks and other common architectural problems will also lead to villa basement leakage damp mildew.
3, when the basement concrete structure in the electron microscope to see its internal, is actually the transparent structure, which is full of capillary channel, this is due to the joined a lot of water when mixing concrete, concrete hydration hardening finished, excess water to ran out from inside the concrete, to form a large number of capillary channel, if you don't cut off the source of water vapor, The water vapor will directly enter the interior of the basement of the villa through these concrete capillary channels, which is the reason why the basement of many villas is still wet even after the dehumidifier is installed.
4, concrete and cement mortar after hydration to produce large amounts of calcium hydroxide, the calcium hydroxide to acicular form within the concrete capillary channel, calcium hydroxide alkaline material, easy to absorb moisture, when the concrete temperature rise, the moisture will slowly evaporates, send out in the basement space, especially in the southern region the rainy season, The humid air outside also enters the interior of the basement of the villa through the doors and Windows. When two kinds of humid gas are superimposed, there will be a lot of condensed water on the walls and ground of the basement of the villa. This is the root cause of the damp and moldy basement of the villa.
5, villa basement waterproof coatings, waterproofing materials, internal do cement-based permeable crystallization type waterproof coating is not can moisture-proof, waterproof coating, waterproof coiled material to do inside the villa basement while it is possible to cut into the basement water vapor source, but after waterproof coatings, waterproofing materials, to do outside protective layer, the protective layer is generally cement mortar or concrete, The problem lies in this protective layer. Ordinary cement mortar and concrete concrete have a large amount of calcium hydroxide inside, which is easy to absorb moisture. When the temperature rises inside the basement, a large amount of water vapor begins to volatilize out, rapidly increasing the humidity of the basement. So ordinary cement mortar and concrete concrete is also wet source!

The root of the villa, there is always a little musty basement, after find out the best way is to install the electroosmosis pulse permeability dehumidification system, TQ - EPT is simply through indoor host control part, decorate in the indoor wall surface between the anode and outdoor in the soil of the cathode of specific frequency pulse, to channel water molecules oriented in outdoor.

So that the basement to achieve a dry environment, no longer moldy damp trouble. Let you have a livable underground space.
